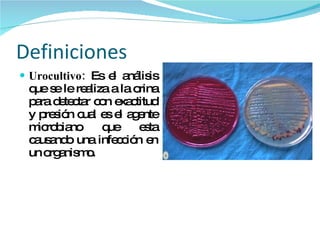

El urocultivo es un análisis de orina que detecta agentes microbianos que causan infecciones. La muestra ideal es la primera orina de la mañana. Se requieren de 3 a 5 ml de orina estéril en un frasco. Los principales microorganismos que causan infección urinaria son E. coli, Klebsiella pneumoniae y Proteus mirabilis. El recuento de colonias en placa o método del asa calibrada cuantifican las bacterias en la orina para diagnosticar una infección.